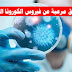
حقائق مرعبة عن فيروس الكورونا القاتل

الأرشيف
عودة شباب سوريين من تركيا الى ادلب للانضمام الى الجــ.يش الوطني السوري
عودة شباب سوريين من تركيا الى ادلب للانضمام الى الجــ.يش الوطني السوري نشرت وسائل إعلامية تركية مساء أمس الجمعة تقريراً مصوراً يظهرعودة شبان سوريين من ولاية “كهرمان مرعش ” التركية إلى…
قراءة المزيد اخبار متفرقة من تركيا والعالم العربي
اخبار متفرقة من تركيا والعالم العربي
الأتحاد الأوروبي يحسم قضية اللاجئين على أبواب اليونان !
واخيرا الاتحاد الأوروبي يتكلم بخصوص اللاجئين على أبواب اليونان صرّح رئيس الوزراء اليوناني كيرياكوس ميتسوتاكيس، بأن بلاده ليس لها يد في الأحداث التي تعيشها سوريا، وإنها لن تتسامح مع …
قراءة المزيد صحة
صحة
حقائق مرعبة عن فيروس الكورونا القاتل
حقائق مرعبة عن فيروس الكورونا القاتل 1- حجم الفيروس يعد كبيرا, حيث ان كل قطر خلية هو 400-500 نم, ولهذا فإن أي قناع ممكن ان يمنع دخولها . مع ذلك عندما يقوم شخص بالعطس أمامك سيأخذ الفيروس مسافة 3 امتار قبل ان يسقط على الأرض ول…
قراءة المزيد واتس اب
واتس اب
اطلاق نسخة واتساب طد الحظر او الباند
اطلاق نسخة واتساب طد الحظر او الباند نضع بين أيديكم مميزات أهم تطبيق مراسلة على الإطلاق من بين تطبيقات المراسلات الفورية ألأ وهو تطبيق واتس اب الذهبي الذي تربع على عرش أهم التطبيقات في العالم العربي واحتل المركز الأول في أكثر تطبي…
قراءة المزيد الربح من الانترنت
الربح من الانترنت
فيسبوك تعتزم منح المستخدمين مالًا مقابل منشوراتهم الشخصية
فيسبوك تعتزم منح المستخدمين مالًا مقابل تسجيلاتهم الصوتية أعلنت شركة فيسبوك يوم الخميس أنها ستعرض دفع المال لبعض المستخدمين مقابل تسجيلاتهم الصوتية التي ستُستخدم للمساعدة في تحسين ت…
قراءة المزيد
